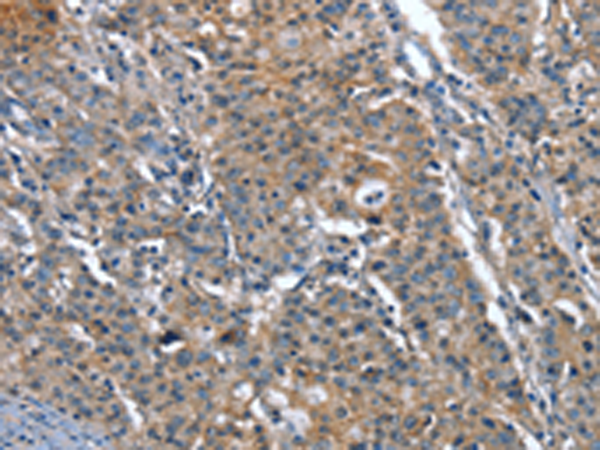
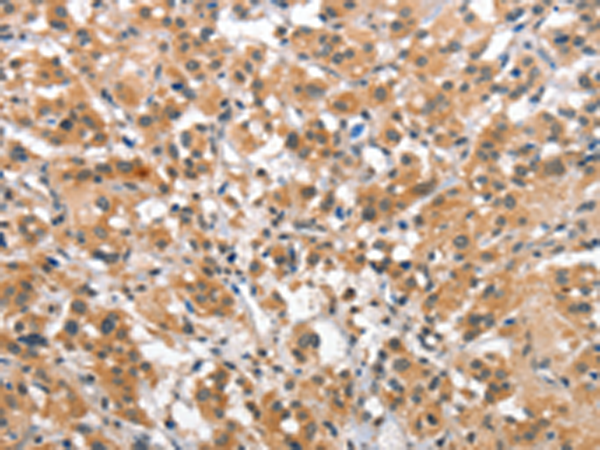
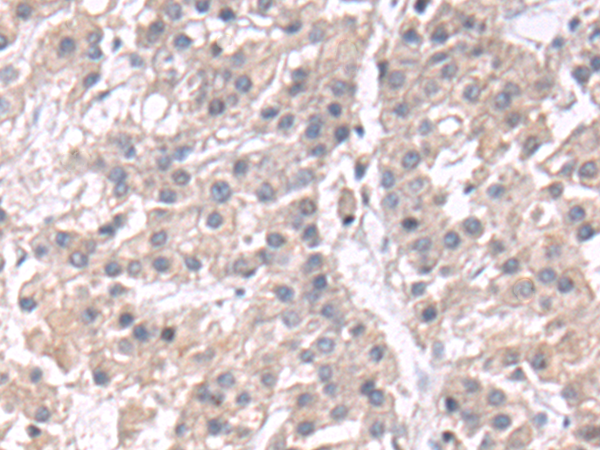

-
分类: 科研抗体货号: P04704别名: ASB; G4S; MPS6应用: WB,IHC反应种属: Human
-
分类: 科研抗体货号: P04769别名: CD318; TRASK; SIMA135应用: WB,IHC反应种属: Human
-
分类: 科研抗体货号: P04734别名: GVI; PLA2; INAD1; NBIA2; iPLA2; NBIA2A; NBIA2B; PARK14; PNPLA9; CaI-PLA2; IPLA2-VIA; iPLA2beta应用: IHC反应种属: Human, Mouse, Rat
-
分类: 科研抗体货号: P04694别名: BSP1; JV41; BSP-1; JV4-1; MADH1; MADR1应用: IHC反应种属: Human, Mouse, Rat
-
分类: 科研抗体货号: P04763别名: CDK11; CDC2L6; EIEE87; bA346C16.3应用: WB,IHC反应种属: Human, Mouse
-
分类: 科研抗体货号: P04806别名: DIA1R; CXorf36; PRO3743; EPQL1862; bA435K1.1; 4930578C19Rik应用: WB,IHC反应种属: Human, Mouse
-
分类: 科研抗体货号: P04693别名: LDS3; LDS1C; MADH3; JV15-2; HSPC193; HsT17436应用: WB,IHC反应种属: Human, Mouse, Rat
-
分类: 科研抗体货号: P04762别名: CDC2L2; CDC2L3; p58GTA; PITSLRE; CDK11-p46; CDK11-p58; CDK11-p110 / p58; PK58; CDK11; CLK-1; CDC2L1; p58CLK-1; CDK11-p46; CDK11-p58; p58CDC2L1; CDK11-p110应用: WB,IHC反应种属: Human, Mouse
-
分类: 科研抗体货号: P04804别名: TSBP; p150; SH2BP1; p150TSP应用: WB反应种属: Human, Mouse
-
分类: 科研抗体货号: P04689别名: CLG4; MONA; CLG4A; MMP-2; TBE-1; MMP-II应用: WB,IHC反应种属: Human, Mouse, Rat

鄂公网安备42018502007531号
鄂公网安备42018502007531号

